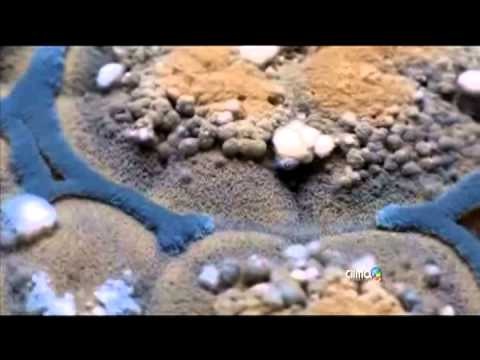
download lagu mp3 mp4 Que Es Mojo, download lagu Que Es Mojo gratis, unduh video klip Que Es Mojo

Que Es Mojo }}- Debido a los altos índices de humedad se desarrolla el moho, una variedad de los hongos que puede tener efectos negativos en nuestra salud.
Before downloading Que Es Mojo Videos , Download and listen MP3 songs free online. Watch new Bollywood songs and latest popular Hindi songs, English and regional movies, TV shows and videos online
Que Es Mojo Download Lyrics Mp3 and Mp4 :
Music Discovery, Charts and Song Lyrics : El Moho, Una Clase De Hongos Que Puede Afectar Nuestra Salud | Que Es Mojo
El moho, una clase de hongos que puede afectar nuestra salud - Que Es Mojo - Debido a los altos índices de humedad se desarrolla el moho, una variedad de los hongos que puede tener efectos negativos en nuestra salud.
Music Discovery, Charts and Song Lyrics : 10 Señales De Que Puedes Estar Sufriendo De Una Enfermedad Relacionada Con El Moho En Tu Casa | Que Es Mojo
10 Señales De Que Puedes Estar Sufriendo De Una Enfermedad Relacionada Con El Moho en tu casa - Que Es Mojo - 10 Señales De Que Puedes Estar Sufriendo De Una Enfermedad Relacionada Con El Moho en tu casa ¿Sabía usted que el moho puede ser la causa de varios ...
Music Discovery, Charts and Song Lyrics : ¿Qué Es El Periodismo Móvil? #mojo | Que Es Mojo
¿Qué es el periodismo móvil? #mojo - Que Es Mojo - Corto sobre algunas características del periodismo móvil. Realizado con las aplicaciones Legend y KineMaster Pro.
Music Discovery, Charts and Song Lyrics : La Historia De Mojo (ORIGEN) - Marvel | Que Es Mojo
La Historia De Mojo (ORIGEN) - Marvel - Que Es Mojo - Hola a todos, no olviden suscribirse y comentar de que personaje quieren que hable en próximos vídeos!!! En Comics Story estaremos subiendo las historias ...
Music Discovery, Charts and Song Lyrics : MOJO CRIOLLO CUBANO Receta Casera ► Como Prepararlo 3 PASOS | Que Es Mojo
MOJO CRIOLLO CUBANO Receta Casera ► Como Prepararlo 3 PASOS - Que Es Mojo - Prepara la receta de este delicioso mojo criollo en tan solo 3 sencillos pasos y realza el sabor de tus comidas. Te muestro cada ingrediente y el paso a paso del ...
Identify the media playing around you Que Es Mojo explore the music you love [ Discover song lyrics from your favourite artists MOJO CRIOLLO CUBANO Receta Casera ► Como Prepararlo 3 PASOS, Que Es Mojo &] Music Mp3 and Mp4 download that gives you an access to thousand of songs. Download free music, free Mp3, Free Mp4, top charts, playlists, new releases and offline listening.
Post a Comment
Post a Comment